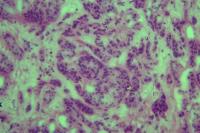

| 图片: | |
|---|---|
| 名称: | |
| 描述: | |
- 胰头肿物性质待诊
-
13668740117 离线
- 帖子:317
- 粉蓝豆:4
- 经验:334
- 注册时间:2012-03-24
- 加关注 | 发消息
-
dy1052691@e 离线
- 帖子:51
- 粉蓝豆:7
- 经验:51
- 注册时间:2014-10-15
- 加关注 | 发消息
-
13668740117 离线
- 帖子:317
- 粉蓝豆:4
- 经验:334
- 注册时间:2012-03-24
- 加关注 | 发消息
会诊结果 :实性假乳头状瘤
-
whyang315: 学习了!2026-01-13 15:24